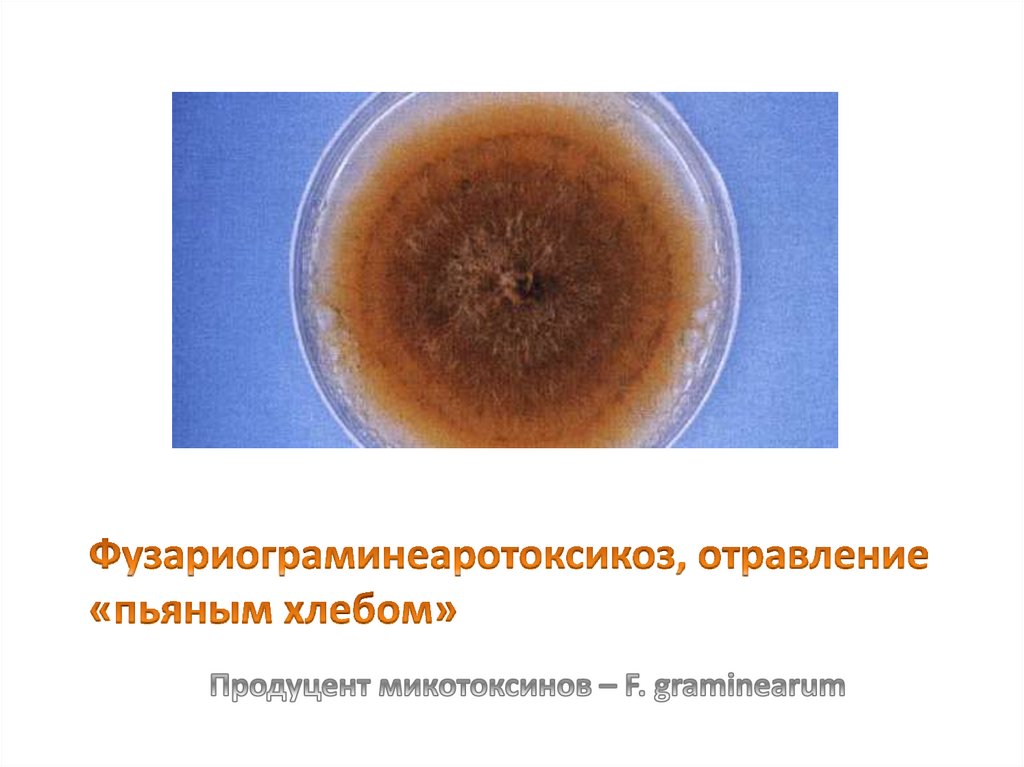
Фузариограминеаротоксикоз, отравление «пьяным хлебом»

Похожие презентации:
lektsiya obschaya gigiena. pitanie i zdorove naseleniya
1. Питание и здоровье населения ЧАСТЬ 1
2.
План лекции• Питание как социальный и один из факторов
сохранения здоровья. Задачи государственной
политики в области здорового питания.
• Оценка состояния питания.
• Современные теории питания.
• Понятие о рациональном питании. Основные
принципы рационального питания.
• Биологические и экологические проблемы
питания.
3.
4. Особенности питания населения Оренбуржья
По сравнению с физиологическими нормами дефицитпотребления составил
- рыбы и рыбопродуктов 55,6%,
- фруктов и ягод - 39%,
- мяса и мясопродуктов - 21,6%,
- молока и молочных продуктов - 23%.
Дефицит ряда важнейших микронутриентов, в том
числе эссенциальных микроэлементов, таких как
йод, фтор, селен и железо
Повышено потребление растительного масла, хлеба и
хлебопродуктов.
5. Роль питания
• Пластическая• Энергетическая
• Регуляторная (источник балластных веществ и
микронутриентов которые участвуют в
образовании ферментов, гормоны и др.) и
приспособительно-регуляторная (адаптогенная).
• Иммунорегулирующая
• Реабилитационная
• Сигнально-мотивационная
6. ПИЩЕВОЙ СТАТУС
Комплекспоказателей,
отражающих
адекватность фактического питания реальным
потребностям
организма,
определяемое
питанием
в
конкретных
социальноэкономических условиях (возраст, пол, труд,
быт ).
ПИЩЕВОЙ СТАТУС:
обычный;
оптимальный;
избыточный;
недостаточный
7. Показатели пищевого статуса
1. Данные физического развития(адекватность энергетической и
пластической сторон питания)
2. Проявления микронутриентного
дисбаланса (витаминно-минерального)
3. Данные лабораторных
исследований (характеристика
отдельных видов метаболизма и др.)
8. Заболеваемость
специфическая (алиментарная –ожирение, дистрофии, пищевые
аллергии),
• неспецифическая (замедление
процессов регенерации,
нарушается нормальный состав
микрофлоры и т.д.).
9. Питательные вещества
— это пищевые (белки, жиры, углеводы, витаминыминеральные соли, вода) и вкусовые
(органические кислоты, кетоны, эфиры,
красители, дубильные вещества и т.д.) вещества.
Пищевые вещества обеспечивают биологические
потребности организма в веществах и энергии, а
вкусовые обеспечивают определенные
органолептические свойства продукта питания.
10. Антипитательные вещества
некоторые аминокислоты, антиминеральныевещества, антивитамины и т.д. Являясь
естественным компонентом пищи, они снижают
ее биологическую значимость за счет нарушения
усвоения соответствующих пищевых веществ
(например, антивитамин аскорбиназа разрушает
аскорбиновую кислоту).
11. Чужеродные химические вещества
остаточные количества пестицидов,радиоактивные вещества, соли тяжелых
металлов, микотоксины, алкалоиды,
нитрозамины, гормоны (эстрогены,
добавляемые в корм животных для их роста),
бета-блокаторы, применяемые для снятия
стрессов у животных, антибиотики — для
лечения и профилактики инфекционных
болезней животных и многие другие. Они
оказывают на организм неблагоприятное
воздействие.
12. Положения теории адекватного питания
• Питание должно поддерживать молекулярный состав ипокрывать энергетические и пластические затраты
организма на основной обмен, внешнюю работу и рост.
• Необходимыми компонентами пищи служат не только
пищевые вещества но и балластные.
• Нормальное питание обусловлено поступлением в
организм не только пищевых. Но и других (регуляторных)
веществ, которые имеют жизненно важное значение.
• Вторичные полезные соединения образуются из балластных
веществ по влиянием бактериальной флоры кишечника.
13. Виды питания
• Рациональное питание• Превентивное (рациональное
профилактическое) питание.
• Лечебно-профилактическое питание.
• Лечебно – диетическое питание
14. РАЦИОНАЛЬНОЕ питание
• это правильно организованное исвоевременное снабжение организма
питательной и вкусной пищей, содержащей
оптимальное количество различных
пищевых веществ, необходимых для его
развития, функционирования и
обеспечивающее постоянство внутренней
среды организма.
15. Принципы рационального питания.
1. Количественная характеристика.Энергетическая ценность суточного рациона
соответствует энерготратам организма.
2. Качественный химический состав и
химическая структура пищи
должны соответствовать ферментным
пищеварительным системам организма.
16. Принципы рационального питания.
3. Сбалансированность пищевых веществ.Баланс энергонесущих макронутриентов
и сбалансированность микронутриентов.
4. Соблюдение режима и условий питания.
5. Безвредность и легкоусвояемость пищи
17.
Энергетический баланс - равновесноесостояние между поступающей с пищей
энергией и ее затратами.
Энерготраты суточные – сумма суточных
энерготрат организма, состоящая из
энерготрат основного обмена, затрат энергии
на физическую активность, специфическое
динамическое действие пищи (пищевой
термогенез), холодовой термогенез, рост и
формирование тканей у детей и
дополнительных затрат энергии у
беременных и кормящих грудью женщин.
18. Половозрастные группы населения
Половозрастные группы населения• мужчины и женщины
-18-29 лет,
- 30-39 лет,
-40-59 лет,
• лица пожилого возраста: мужчины и
женщины старше 60 лет
19. Группы населения, дифференцированные по уровню физической активности
• I группа (очень низкая физическая активность; мужчины иженщины) – работники преимущественно умственного
труда
• II группа (низкая физическая активность; мужчины и
женщины) – работники занятые легким трудом
• III группа (средняя физическая активность; мужчины и
женщины) – работники средней тяжести труда
• IV группа (высокая физическая активность; мужчины и
женщины) – работники тяжелого физического труда
• V группа (очень высокая физическая активность;
мужчины) – работники особо тяжелого физического
20.
Химический составпищи
белки
жиры
углеводы
витамины
минеральные
вещества
вода
21. Функциональное деление пищевых веществ:
• преимущественно энергетические –(жиры, углеводы)
• - преимущественно пластические
(белки, ряд минеральных веществ и
вода)
• - преимущественно каталитические
(витамины, микроэлементы)
22. Качественный принцип питания
Физиологическая потребность для взрослого населения• -в белке - 65 - 117 г/сутки для мужчин, и от 58 до
87 г/сутки для женщин.
-в жирах – от 70 до 154 г/сутки для мужчин и от 60
до 102 г/сутки для женщин
- в усвояемых углеводах для взрослых 50-60 % от
энергетической потребности ( 257 - 586 г/сутки)
- в пищевых волокнах для взрослых : 20 г/сутки, для
детей 15-20г/сутки.
- Витамины (жиро- и водорастворимые)
- Минеральные вещества (макро- и микроэлементы)
23. Сбалансированность питания
• Для взрослых доля белков животного происхожденияот общего количества белков – 50%.
• Потребление насыщенных жирных кислот должно
составлять не более 10% от калорийности суточного
рациона, мононенасыщенных жирных кислотах для
взрослых должно составлять 10%, ПНЖК – 6-10 %.
• Потребление добавленного сахара не должно
превышать 10% от калорийности суточного рациона
Соотношение Б : Ж : У; Микроэлементов
24.
25. ФУНКЦИИ БЕЛКОВ
• обеспечивают структуру икаталитические функции ферментов и
гормонов;
• пластические процессы, связанные с
ростом, развитием и регенерацией клеток;
• выполняют защитные функции;
• принимают участие в энергетическом
обмене организма при недостатке
углеводов и жиров.
26. ФУНКЦИИ ЖИРОВ
являются структурным компонентом тела;• служат важнейшим поставщиком энергии;
• являются растворителем витаминов А, Д,
Е, К;
• являются источником незаменимых
факторов питания – ПНЖК, стеринов,
фосфатидов;
• повышают вкусовые свойства пищи и
способствуют более длительной
насыщаемости.
27. ДЕФИЦИТ ПНЖК (линолевая, линоленовая, арахидоновая) приводит к:
• сухости и экзематозным поражениям кожи;• нарушению эластичности сосудов;
• увеличению содержания холестерина в крови;
• образованию язв желудка и двенадцатиперстной
кишки;
• задержке роста, угнетению репродуктивной ф-ии;
• снижению сопротивляемости организма;
• снижению синтеза простагландинов.;
• нарушению обмена витаминов группы В
• склонности к инфекционным заболеваниям;
• возникновению злокачественных новообразований.
28. УГЛЕВОДЫ
Суточная потребность – 400-500 г.• 60 % поступают в организм с
зерновыми продуктами;
• 15-25 % - с сахаром и
кондитерскими изделиями;
• 7 % - с овощами и фруктами
• 10 % - с корнеплодами
29.
Углеводымоносахариды
дисахариды
полисахариды
30. Углеводы усвояемые неусвояемые
усвояемыеУглеводы
глюкоза, сахароза,
лактоза, фруктоза,
мальтоза,
альфа-глюконовые
полисахариды :
гликоген
декстрины
крахмал
неусвояемые
пектиновые в-ва
лигнин
целлюлоза
гемицеллюлоза
31. витаминоподобные вещества
• ПНЖК- F• В15 – пангамовая кислота
• Н1 – парааминобензойная кислота
• холин – В4
• инозит – В8
• карнитин
• витамин U
• оротовая кислота – В13
32. АВИТАМИНОЗЫ
• С – авитаминоз (цинга)• В1 – авитаминоз - бери-бериалиментарный полиневрит
• РР – авитаминоз - пеллагра
• Д – авитаминоз - рахит
• А – витаминоз - гемералопия
ксерофтальмия
33. ФУНКЦИИ МИНЕРАЛЬНЫХ ВЕЩЕСТВ
• -участие в биохимических процессах;• - пластическая функция (основа скелета);
• - поддержание коллоидного состояния протоплазмы;
• - осмотическое давление;
• - поддержание концентрации водородных ионов;
• - буферные свойства крови;
• - транспорт белков и углеводов через клеточные
мембраны (медь, железо, магний);
• - процесс свертываемости крови (кальций);
• - перемещение газов крови (железо);
• - в процессах возбудимости нервной и мышечной ткани
(калий, кальций, натрий);
• - обеспечение нормализации водно-солевого обмена.
34. макроэлементы
кальций, фосфор, магний,натрий, железо, калий
микроэлементы
йод, фтор, селен, молибден,
ванадий, кобальт, цинк,
марганец, хром, медь
35. Критерии режима питания:
• Регулярность питания.• Дробность питания в течении суток: 2-х
разовое; 3-х — 4 -х и т.д.
• Соблюдение рационального питания при
каждом приеме пищи.
• Наиболее физиологическое распределение
пищи по ее приемам в течении дня.
36.
• Усвояемость пищи определяется с однойстороны сбалансированностью и качественным
составом пищи, а с другой кулинарной
обработкой продуктов и пищи.
• Безвредность определяется
доброкачественным составом питательных
компонентов в продуктах, а так же наличием
ксенобиотиков химического и биологического
характера.
37. Рекомендации
• 1 Ешьте питательную пищу, в основе которой лежатразнообразные продукты главным образом овощи и
фрукты, предпочтительно в свежем виде и местного
происхождения (не менее 400 г в день).
• 2. Несколько раз в день ешьте хлеб, зерновые
продукты, макаронные изделия, рис или картофель.
• 3. Контролируйте потребление жиров (не более 30%
суточной энергии) и заменяйте большую часть
насыщенных жиров ненасыщенными растительными
маслами или мягкими маргаринами.
38.
4. Заменяйте жирные мясо и мясныепродукты фасолью, бобами, чечевицей,
рыбой, птицей или нежирным мясом.
5.Употребляйте молоко и молочные
продукты (кефир, простоквашу, йогурт и
сыр) с низким содержанием и жира, и соли.
б.Выбирайте такие продукты, в которых
мало сахара, и поменьше употребляйте
рафинированного сахара, ограничивая
частоту употребления сладких напитков и
сладостей.
39. Алиментарные заболевания. Пищевые отравления и их профилактика Часть 2
40. ПЛАН
1. Алиментарные заболевания.2. Классификация пищевых отравлений.
3. Пищевые отравления микробной
природы.
4. Микотоксикозы.
5. Пищевые отравления немикробной
природы
41. Алиментарные заболевания (лат. alimentarius пищевой) — болезни, обусловленные недостаточным или избыточным по сравнению с
АЛИМЕНТАРНЫЕЗАБОЛЕВАНИЯ (ЛАТ.
ALIMENTARIUS ПИЩЕВОЙ) —
БОЛЕЗНИ, ОБУСЛОВЛЕННЫЕ
НЕДОСТАТОЧНЫМ ИЛИ
ИЗБЫТОЧНЫМ ПО СРАВНЕНИЮ С
ФИЗИОЛОГИЧЕСКИМИ
ПОТРЕБНОСТЯМИ
ПОСТУПЛЕНИЕМ В ОРГАНИЗМ
ПИЩЕВЫХ ВЕЩЕСТВ.
Алиментарные заболевания в своем большинстве относятся к :
IV классу – Болезни эндокринной системы, расстройства питания и нарушения
обмена веществ,
I классу - Инфекционные и паразитарные заболевания и
XIX классу - Травмы и отравления и некоторые другие последствия воздействия
внешних причин
42. I. Недостаточное питание (коды Е40- Е64 по МКБ 10)
1. Болезни белковой и калорийнойнедостаточности (код Е64 по МКБ 10
пересмотра) :
- квашиоркор,
- маразм;
- алиментарная дистрофия
2. Недостаточность минеральных веществ:
йода; фтора; селена; кальция; прочих элементов;
3. Недостаточность витаминов;
4. Другие болезни пищевой недостаточности:
недостаточность незаменимых жирных кислот;
недостаточность отдельных аминокислот; другие
состояния.
43. Основной признак квашиоркора
наличие триады:- отеки вследствие недостаточного
поступления полноценного белка;
- гипоальбуминоанемия;
- гепатомегалия.
44. Алиментарный маразм - состояние энергетического дефицита или сочетание энергетического дефицита с падением периферических
запасов белков• Чаще развивается у детей первого года жизни;
• вследствие общей недостаточности всех пищевых веществ (при
голодании).
• определяется в основном по антропометрическим показателям,
дефицит массы – до 60 % и более.
• больные с алиментарным маразмом апатичны, но в ясном
сознании, выпадающие тусклые, сухие волосы, выпадают,
Кожные покровы сухие, неэластичные, морщинистые, выглядят
старше своего возраста («маленький старичок»), что связано с
отсутствием подкожно-жировой клетчатки на лице.
• рвота при употреблении пищи, диарея, брадикардия, снижение
АД, гипотермия до 35,5 С.
45. Классификация алиментарной гипотрофии по этиологии:
• 1. Алиментарная гипотрофия первичного генеза.• - при физических нагрузках;
• - при стрессах;
• - при соблюдении гипокалорийных несбалансированных диет
(недостаток незаменимых аминокислот, жирных кислот и
жирорастворимых витаминов);
• - при низких доходах, голодании, когда снижена энергетическая ценность
пищи, при качественных изменениях рациона.
46. Классификация алиментарной гипотрофии по этиологии:
2. Алиментарная гипотрофия вторичного генеза.• - при нервной анорексии и психических расстройствах,
при неврозах; злокачественных новообразованиях
• - при заболеваниях, препятствующих поступлению и
усвоению пищи (синдромы недостаточности
пищеварения, нарушения усваимости пищи);
• - при хирургических состояниях: стеноз пищевода,
привратника, стриктуры и ожоги пищевода, желудка и др.
47. Стадии алиментарной гипотрофии
• 1 стадия - понижение питания, поллакиурия,усиление аппетита, жажда, стремление к повышенному
потреблению поваренной соли. Общее состояние резко
не страдает.
• 2 стадия - отчетливое похудание, ухудшение общего
состояния, мышечная слабость, снижается
трудоспособность, появляются гипопротеинемические
отеки на ногах, повышенный аппетит и жажда, поли- и
поллакиурия, начальные дистрофические изменения во
48. Стадии алиментарной гипотрофии
• 3 стадия –кахексия, полное исчезновение подкожно-жировойклетчатки, атрофия мышц, резкая слабость, апатия, выраженные
изменения психики в виде депрессии и заторможенности,
полигиповитаминоз, признаки печеночной, сердечной
недостаточности, анемия, запоры, обложен язык, сглажены сосочки,
«географический язык», снижение кислотообразующей,
секреторной и протеолитической функции желудка, а также
гипопротеинемия, преимущественно за счет снижения альбумина,
развитие выраженной гипотермии (до 30◦С), гипотензия, ацидоз.
Угнетен иммунитет, снижение уровня иммуноглобулинов,
присоединение инфекционные заболевания. При отсутствии
медицинской помощи голодная кома и смерть.
49. О роли красного мяса в развитии ожирения и рака
• 3. Официально установлено, говядина, свинина,баранина являются потенциальными канцерогенам . При
ежедневном потреблении 100 граммов – повышается риск
рака прямой кишки на 17%. Самыми вредными являются
продукты промышленной переработки (сосиски,
колбасы.,копчености) при ежедневном потреблении 50 г,
риск рака кишечника увеличивается на 18%.
50. Рейтинг полезности растительных масел
• По содержанию ПНЖК:• Льняное масло
• Рапсовое масло
• Оливковое масло
• Подсолнечное масло
• Соевое масло
51. III. Пищевые отравления (коды А00- В99 и Т51-Т64 по МКБ 10)
Пищевые отравления – острые заболевания,возникающие в результате употребления пищи,
массивно обсемененной определенными видами
микроорганизмов или содержащей токсичные для
организма вещества микробной или немикробной
природы
52. ГИГИЕНИЧЕСКАЯ КЛАССИФИКАЦИЯ ПИЩЕВЫХ ОТРАВЛЕНИЙ (по К.С.Петровскому)
ГИГИЕНИЧЕСКАЯ КЛАССИФИКАЦИЯ ПИЩЕВЫХ)
ОТРАВЛЕНИЙ (по К.С.Петровскому
I. Пищевые отравления микробной этиологии
1. Пищевые токсикоинфекции:
а) бактерии рода Е. соli (энтеропатогенные серотипы);
б) бактерии рода Proteus (Proteus vulgaris et mirabilis);
в) энтерококки (Str. faecalis var. liguefaciens et zymogenes);
г) спороносные аэробы (Вас. cеreus);
д) спороносные анаэробы (Cl. рerfringens);
е) патогенные галлофилы (Vibrio parahaemoliticus);
ж) малоизученные микроорганизмы (Citrobacter, Hafnia,
Klebsiella и др.
53. Токсикоинфекции – это острые заболевания, возникающие при употреблении пищи, содержащие большое количество (105-106 и более на
Токсикоинфекции – это острые заболевания, возникающиепри употреблении пищи, содержащие большое количество (105106 и более на 1 гр. или 1 мл. продукта) живых возбудителей и их
токсинов.
Характерные признаки:
1. Внезапное развитие вспышки при очень коротком
инкубационном периоде.
2. Почти одновременное заболевание всех потребляющих одну и
ту же пищу.
3. Выраженная связь заболеваний с употреблением определенной
пищи.
4. Территориальная ограниченность заболеваний.
5. Быстрое прекращение вспышки после изъятия опасного
продукта.
6. Массовый характер заболеваний, когда продукт использован
централизованно ( общепит).
54. ГИГИЕНИЧЕСКАЯ КЛАССИФИКАЦИЯ ПИЩЕВЫХ ОТРАВЛЕНИЙ (продолжение)
2. Пищевые токсикозы:а) Бактериотоксикозы –
- энтеротоксигенные стафилококки (Staphylococcus aureus);
- ботулизм (Clоstridium Botulinum).
б) Пищевые отравления грибковой природы - микотоксикозы:
- грибы рода Aspergillus;
- рода Fusarium;
- грибы рода Claviceps purpurea и др.
3. Миксты (пищевые отравления смешанной
этиологии):
- Вас. cеreus и энтеротоксигенный стафилококк
- Вас. рrоteus и энтеротоксигенный стафилококк
55. СТАФИЛОКОККОВЫЙ ТОКСИКОЗ (код по МКБ-10 А05.0) – возбудитель золотистый стафилококк: 5 энтеротоксинов. Основной природный
резервуар -человек /носоглотка, гортань, кожа/. До 40-50%практически здоровых людей являются носителями стафилококков.
Считают, что стафилококковые токсикозы являются причиной почти 21%
всех пищевых отравлений.
Инкубационный 2-4 часа, t тела нормальная или субфебрильная.
Тошнота, рвота, боли в животе. В 60-70% - понос. Явление общей
интоксикации. Выздоровление через сутки, реже 2-3 дня.
Оптимальная t для размножения – не ниже 22С , при 12-15С
размножение резко замедляется, а в условиях холодильника 4-6С
прекращается. Самая благоприятная среда – молоко и молочные
продукты, салаты, котлеты, торты, пирожные .
56. БОТУЛИЗМ (код по МКБ-10 А05.1)– от лат. «botulus» – колбаса. Возбудитель – Cl. Botulinum, выделен Э. Ванэрменгемом в 1896г. в
Голландии после вспышки тяжелого отравления, связанного светчиной.
Существуют 7 типов – А,В,С,Д,Е, F и G. Токсин очень токсичен,
превосходит по токсичности все известные токсины. Введение
0,05мг сухого токсина смертельно для человека. Инкубационный
период от 2-3 часов до 6-10 суток. За этот период токсин
всасывается и мигрирует в ЦНС, где происходит необратимая
фиксация яда.
Выделяют 4 формы:
1. ботулиновый острый гастроэнтерит
2. диспепсическо – паралитическая
3. офтальмопаралитическая
4. асфиксическая
57. Пищевые отравления грибковой природы –афлатоксикоз; главные продуценты афлотоксинов: A.flаvus u A.parasiticus. Вызывают острую
и хроническую интоксикацию, атакже отдаленные эффекты, в т.ч. гонадотоксическое,
эмбриотоксическое, тератогенное, мутагенное и
канцерогенное действие.
При афлатоксикозе главным органом – мишенью
является печень – цирроз, рак.
58. Пищевые отравления грибковой природы - микотоксикозы: ФУЗАРИОЗЫ – вызываются грибками рода Fusаrium, включают алиментарно -
Пищевые отравлениягрибковой природы микотоксикозы: ФУЗАРИОЗЫ – вызываются грибками
рода Fusаrium, включают алиментарно - токсическую
алейкию (септическая ангина) - развивается при
употреблении в пищу хлеба из перезимовавших в поле
злаковых культур и
отравление « пьяным хлебом» - в результате употребления
в пищу изделий из различных видов зерна, пораженного
микроскопическим грибком Fusarium graminearum.
59. Стадии АТ алейкии
Ангинозно-геморрагическиепоражения
Острый гастроэнтерит; лейкопения
Поражения ЦНС с прогрессирующей
лейко- и тромбоцитопенией
60.
Токсин Т-2, вырабатываемый грибами видаFusarium sporotrichoides
Вырабатывается при температуре 0°С
Сохраняется в зерне до 4-5 лет
Выдерживает высокую температуру
Устойчив к замораживанию, высушиванию,
воздействию ионизирующего и ультрафиолетового
излучений
61. Фузариограминеаротоксикоз, отравление «пьяным хлебом»
62.
Слабость,чувство
тяжести в теле
Нарушение
сознания,
эйфория
Скованность
походки
Диарея, рвота
Головокружение
головная боль
Психические
расстройства
63. Особенности протекания споротрихиеллотоксикоза
Инкубационный период 5-6дней
Первые проявления – через 1-2
ч после употребления хлеба
Глубокое поражение
кроветворной ткани
64. ЭРГОТИЗМ – отравление продуктами, содержащими в качестве примеси спорынью. Чаще это - хлебные изделия из зерна и муки,
содержащиерожки спорыньи, т.е. мицелии гриба. ПДК спорыньи
в муке - 0,05%.
Формы: 1. Конвульсивная.
2. Гангренозная.
3. Смешанная.
65. Эрготизм
66. 8 апреля 1946 г. Лев Ефимович Олифсон был назначен руководителем первой научной экспедиции по изучению септической ангины,
организованнойОренбургским медицинским институтом в
Александровском и Переволоцком районах.
Тема “Микотоксины” стала главной
в его научной деятельности,
напечатано около 70 работ.
Материалы по изучению химической
деятельности микроскопических плесневых
грибов, полученные Л.Е. Олифсоном и его
учениками, вошли во все учебники,
издаваемые в СССР по санитарной и
ветеринарной микологии, а также нашли
отражение в публикациях многих зарубежных
учёных, в том числе в США, Японии, Англии,
Чехословакии, Болгарии
67. В 1980 г. Л. Е. Олифсон получил авторское свидетельство на изобретение «Способ определения фузариотоксинов в зерне злаковых
культур»(соавторы К. Г. Галкович,
Ш. М. Кенина).
68. ГИГИЕНИЧЕСКАЯ КЛАССИФИКАЦИЯ ПИЩЕВЫХ ОТРАВЛЕНИЙ (продолжение)
II. Пищевые отравления немикробной этиологии1. Отравления продуктами, ядовитыми по своей природе:
А. Растительного происхождения:
- ядовитые грибы; условно съедобные грибы (неправильная кулинарная
обработка);
- дикорастущие и культурные растения;
- сорные растения злаковых культур с ядовитыми семенами;
Б. Животного происхождения:
- икра и молоки некоторых рыб (иглобрюхи,, усач и др.);
- некоторые железы внутренней секреции убойных животных
(надпочечники и др.)
69. Ядовитые грибы – бледная поганка
• Бледная поганка и близкие к ней виды ядовитых грибовсодержат чрезвычайно токсичные соединения:
аманитотоксины.
• Заболевание начинается через 4 – 8 часов со
спастических болей по всему животу, тошноты,
неукротимой рвоты, частого жидкого стула. Частота стула
достигает 20-25 раз в сутки.
Появление рвоты типа
кофейной гущи и примесь крови в кале при
холероподобном характере стула типично для
отравлений бледной поганкой.
70. ГИГИЕНИЧЕСКАЯ КЛАССИФИКАЦИЯ ПИЩЕВЫХ ОТРАВЛЕНИЙ (продолжение)
2. Отравления пищевыми продуктами, ядовитыми приопределенных условиях:
А. Растительного происхождения:
- ядра косточковых плодов персика, абрикоса и др. (амигдалин);
- орешки (семена) бука, тунга, рицинии и др.;
- бобы сырой фасоли, содержащие фазин;
- проросший (зеленый) картофель, содержащий соланин.
Б. Животного происхождения:
- печень, икра и молоки некоторых видов рыб (скумбрия и др.) во
время нереста; мидии;
- мед (при сборе пчелами нектара с ядовитых растений).
71. ГИГИЕНИЧЕСКАЯ КЛАССИФИКАЦИЯ ПИЩЕВЫХ ОТРАВЛЕНИЙ (продолжение)
3. Отравления примесями химических веществ кпищевым продуктам:
- пестициды;
- пищевые добавки (неразрешенные и в
недозволенной дозе);
- примеси, мигрирующие в пищу из оборудования,
инвентаря, тары и т.д.( соли тяжелых металлов;
мышьяк, химические вещества синтетических
полимерных материалов)
72. ГИГИЕНИЧЕСКАЯ КЛАССИФИКАЦИЯ ПИЩЕВЫХ ОТРАВЛЕНИЙ (продолжение)
III. Отравления неустановленной этиологии(код Т65 по МКБ 10)
- алиментарная пароксизмальная миоглобинурия
(Гаффская болезнь);
- болезнь Кашина-Бека (Уровская болезнь)
73. Уровская болезнь или болезнь Кашина-Бека.
Этиология: 1. Алиментарно-токсическаяэтиология, грибы (злаки).
2.Высокое содержание стронция в почве,
продукт при недостатке Са. Получено
название стронциевый рахит .
3.Генетическая обусловленность
заболевания.
74. Гаффская болезнь (пароксизмальная миоглобинурия)
Связано с употреблением некоторых видов хищных рыб - щуки,окуня, судака и др., которые в отдельные годы приобретают
токсические свойства вследствие питания планктоном,
загрязненным ядовитыми веществами.
Природа токсического начала не установлена, при термической
обработке рыбы оно не разрушается. Заболевание проявляется
внезапно возникающими приступами острых мышечных болей, от
которых больной полностью теряет подвижность.
Продолжительность приступа 2-4 суток,
75. Благодарю за внимание !
ПрофессорВ.М.Боев
Благодарю за внимание !

Медицина
Медицина








